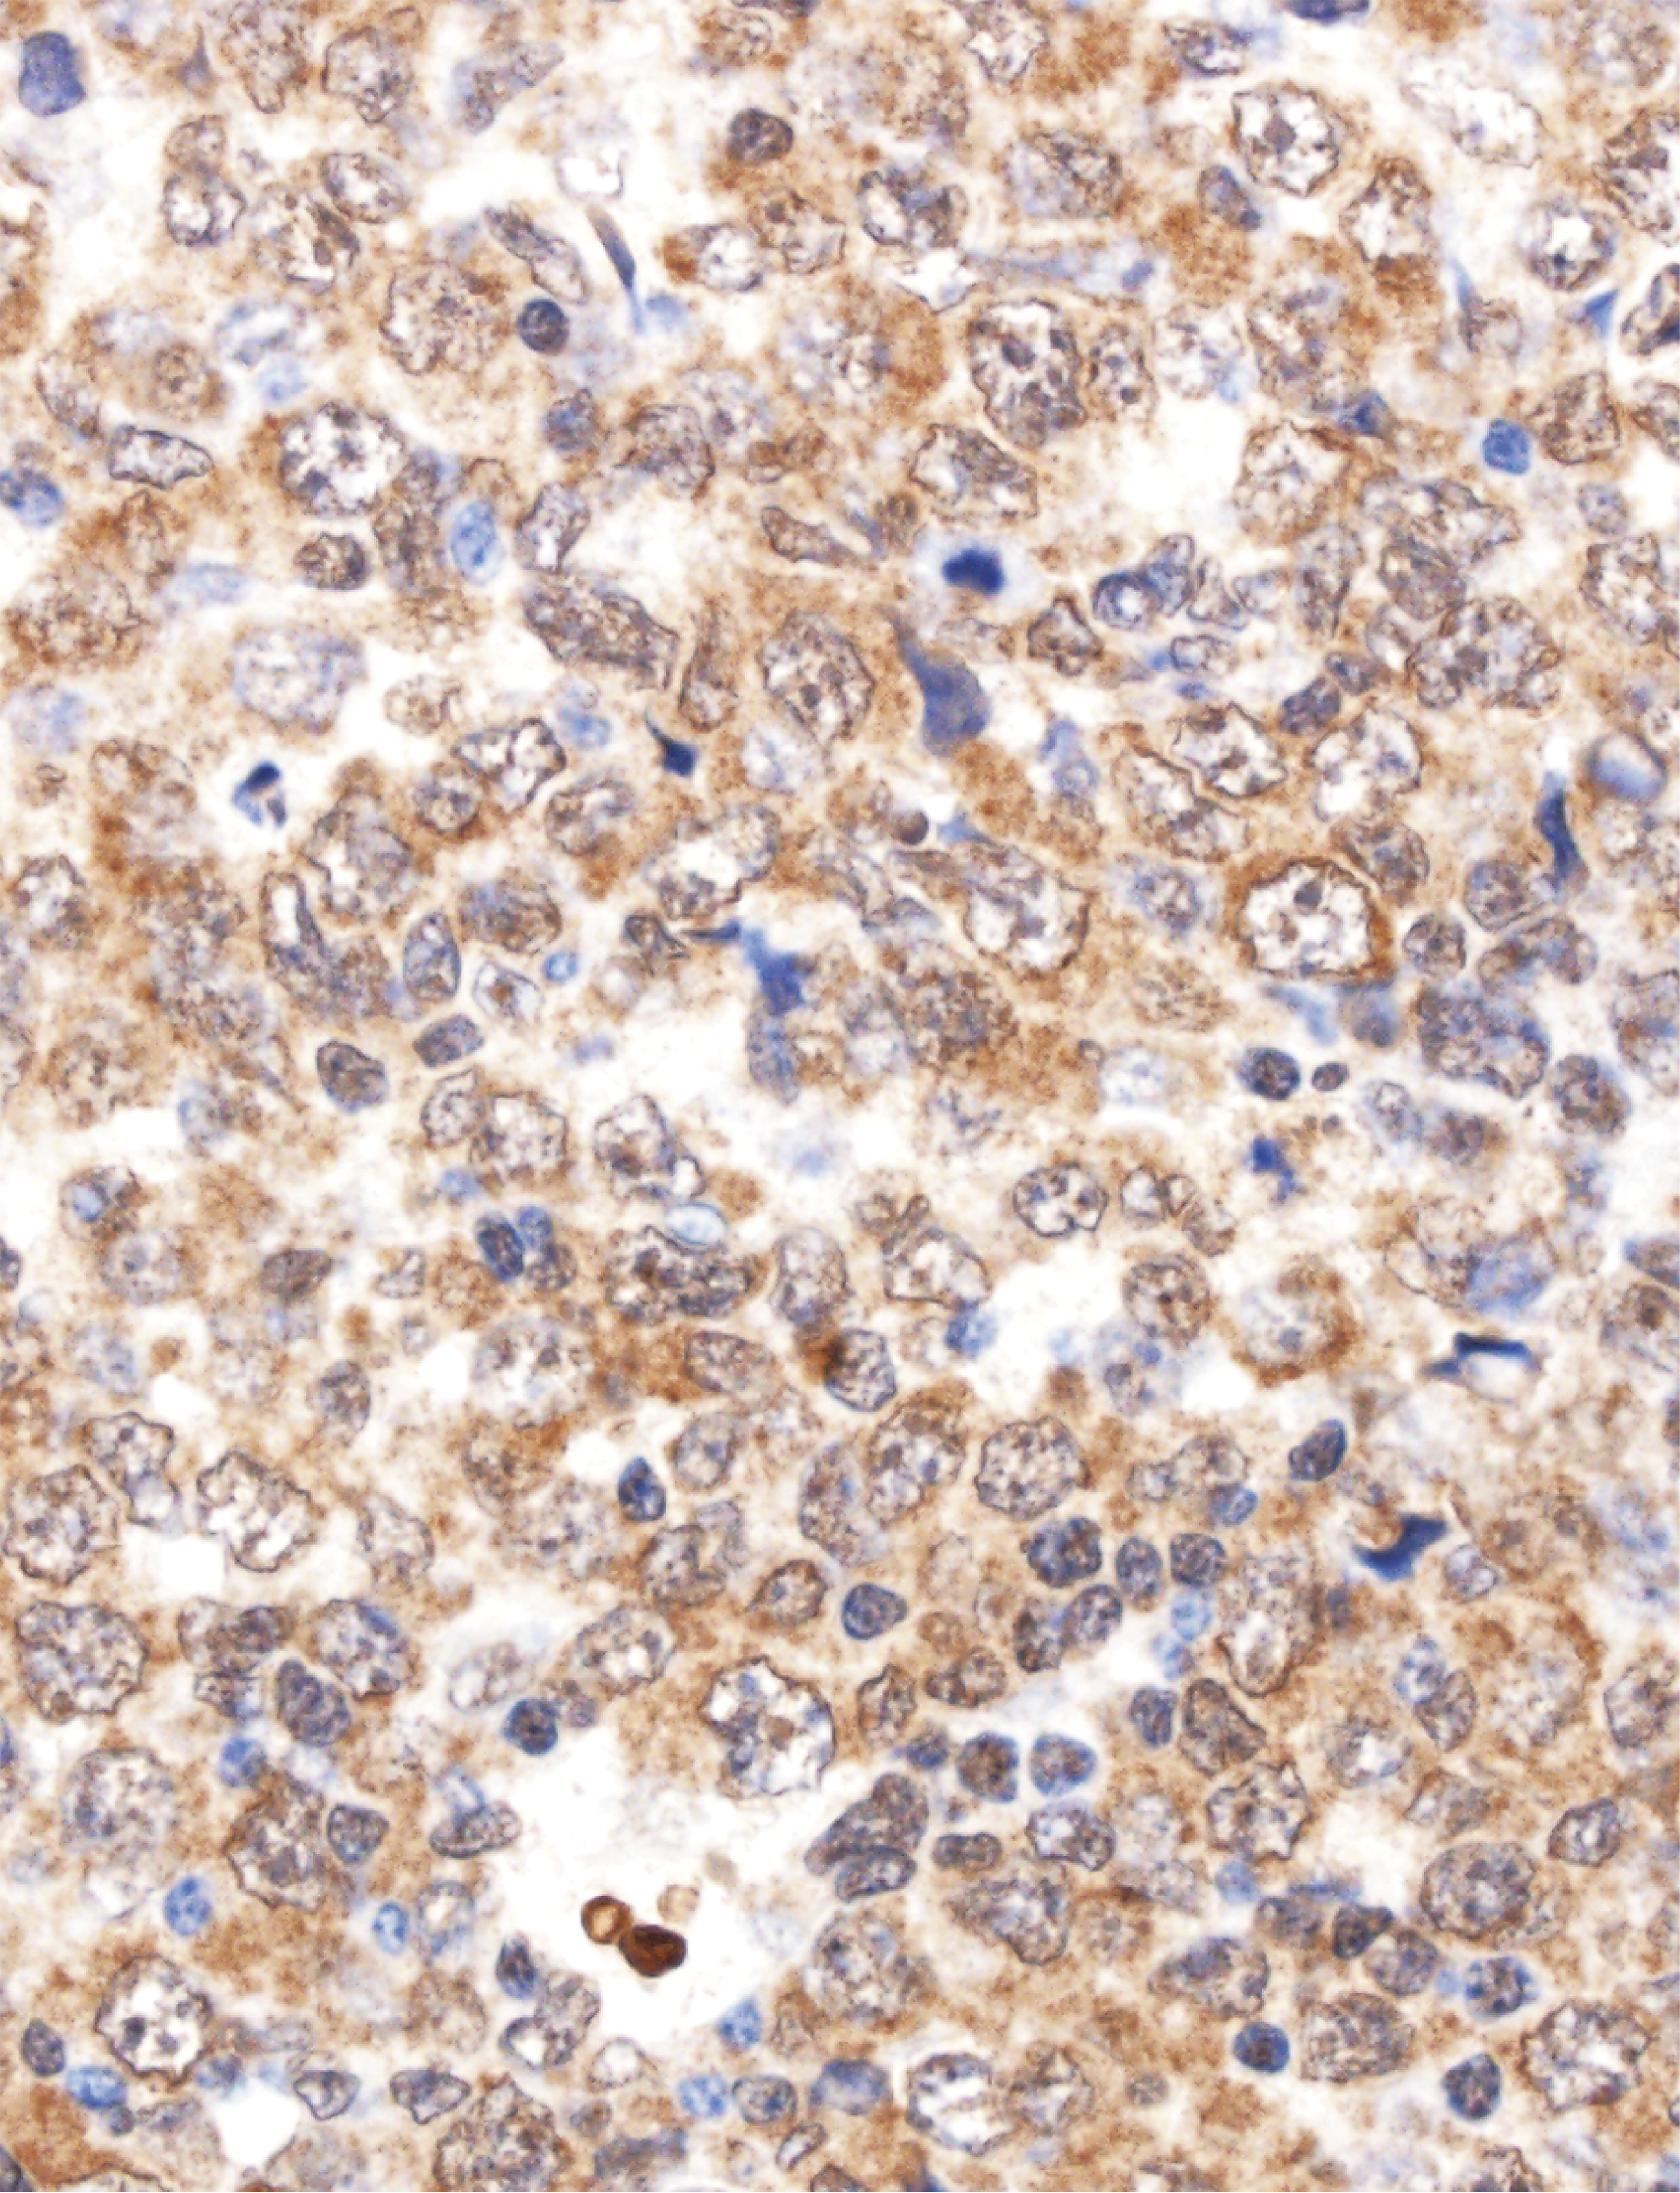
issue cover

Issue Archive
Table of Contents
BLOOD COMMENTARIES
HOW I TREAT
How I manage CLL with venetoclax-based treatments
In this How I Treat article, Wierda and Tambaro discuss the rationale for use of venetoclax in patients with chronic lymphocytic leukemia (CLL) in both the first-line and relapsed and refractory treatment settings. They provide practical guidance for the use of this novel agent that targets BCL2.
CLINICAL TRIALS AND OBSERVATIONS
Assessment of ST2 for risk of death following graft-versus-host disease in pediatric and adult age groups
Clinical Trials & Observations
Rowan and colleagues investigated biomarkers in a prospective multicenter cohort study of nonrelapse mortality after allogeneic stem cell transplantation, identifying plasma levels of stimulation-2 (ST2) prior to transplant as prognostic, independent of significant clinical covariates.
A validated novel continuous prognostic index to deliver stratified medicine in pediatric acute lymphoblastic leukemia
Clinical Trials & Observations
In an international effort examining large prospective data sets, Enshaei et al demonstrate that by using a continuous variable analytical approach, a limited set of well-established prognostic factors in childhood acute lymphoblastic leukemia can improve prediction of outcomes compared to current risk stratification approaches.
Oral brincidofovir decreases the incidence of HHV-6B viremia after allogeneic HCT
Clinical Trials & Observations
Brief Report
Human herpesvirus 6B (HHV-6B) frequently reactivates after allogeneic hematopoietic cell transplantation (HCT). In a post hoc analysis of a randomized trial of cytomegalovirus prophylaxis, Hill et al found that brincidofovir prophylaxis reduces HHV-6B reactivation after allogeneic HCT.
IMMUNOBIOLOGY AND IMMUNOTHERAPY
Nonpermissive bone marrow environment impairs early B-cell development in common variable immunodeficiency
Brief Report
Common variable immunodeficiency is usually considered to be an intrinsic disorder of B-cell development. Troilo and colleagues convincingly show that, in some patients, the defect lies within the bone marrow niche and causes defective B-cell development.
LYMPHOID NEOPLASIA
Reduced–dose intensity therapy for pediatric lymphoblastic leukemia: long-term results of the Recife RELLA05 pilot study
Clinical Trials & Observations
Treating pediatric acute lymphoblastic leukemia is a challenge in resource-limited countries. Pedrosa and colleagues describe the success of an approach that identifies patients at very low risk of relapse and employs a low-intensity chemotherapy regimen for these patients, achieving excellent efficacy and minimal toxicity.
Genomic landscape of young ATLL patients identifies frequent targetable CD28 fusions
Brief Report
Yoshida and colleagues report identification of recurrent fusion genes involving CD28 in more than one-third of young Japanese patients with adult T-cell leukemia/lymphoma (ATLL). They suggest that CTLA4-CD28 fusion may be a pathway amenable to therapeutic targeting with CTLA4 blockade.
MYELOID NEOPLASIA
FLT3 inhibition upregulates HDAC8 via FOXO to inactivate p53 and promote maintenance of FLT3-ITD+ acute myeloid leukemia
Long and colleagues demonstrate that histone deacetylase 8 (HDAC8) upregulation is an important mechanism through which FLT3-ITD+ acute myeloid leukemia cells can persist during tyrosine kinase inhibitor (TKI) therapy. Their data suggest that combining HDAC8 inhibition with TKI treatment could be a promising strategy to treat tyrosine kinase mutation–harboring leukemias.
THROMBOSIS AND HEMOSTASIS
BIVV001, a new class of factor VIII replacement for hemophilia A that is independent of von Willebrand factor in primates and mice
Seth Chhabra et al describe a new factor VIII (FVIII) variant created through protein engineering that has similar functional activity to recombinant or plasma-derived FVIII but with considerably enhanced pharmacokinetic properties. This may enable convenient scheduling to achieve protection against bleeding in conditions of severe hemostatic challenge.
LETTERS TO BLOOD
Topoisomerase 2β mutation impairs early B-cell development
Clinical Trials & Observations
Blinatumomab for infant acute lymphoblastic leukemia
Clinical Trials & Observations
BLOOD WORK
ERRATUM
-
Cover Image
Cover Image
![issue cover]()
Immunohistochemical staining demonstrates CD80 expression (brown) on adult T-cell leukemia/lymphoma cells (blue) with CD28 fusions. Engagement of CD80 by CTLA4-CD28 drives mitogenic signaling but can be blocked with anti-CTLA4 antibodies. See the article by Yoshida et al on page 1467.
- PDF Icon Front MatterFront Matter
- PDF Icon Table of ContentsTable of Contents
- PDF Icon Back MatterBack Matter
- PDF Icon Editorial BoardEditorial Board
Advertisement intended for health care professionals
Email alerts
Advertisement intended for health care professionals

Is antiviral therapy against HHV-6B beneficial?
Clinical Trials & Observations